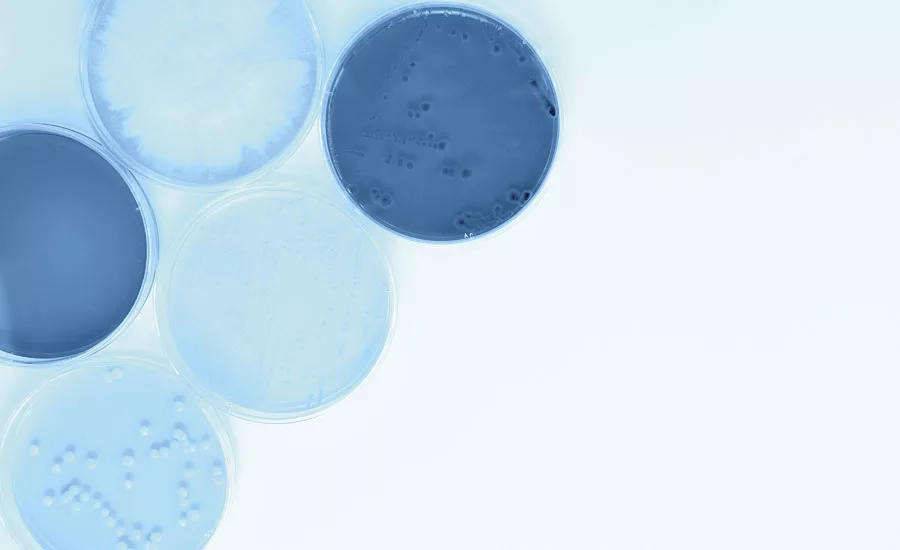
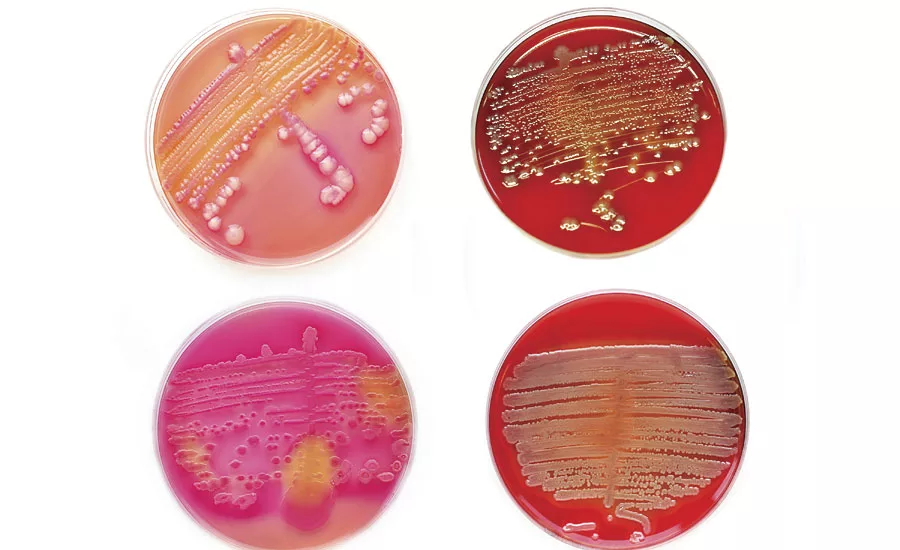

The Rise of Water-Based Formulations
Addressing Microbial Contamination Challenges in the Paint and Coatings Market

For every problem there are solutions. And, for every solution, challenges may arise. As paint and coatings formulators have become increasingly adept at matching the desirable performance characteristics of solvent-based coatings with environmentally preferred, low-VOC, water-based products, they also face microbial growth and contamination challenges.
It’s a well-known premise in the industry: wherever there is water, there are “bugs” - tiny microorganisms capable of contaminating paints, coatings manufacturing facilities and key raw materials. Chemical preservatives, or biocides, are required to control and kill these microorganisms, both in the plant and in the can, to ensure paint and coatings formulations perform optimally. Today, barriers and regulatory limitations placed on the use of industry preservatives have limited the solutions available in our toolbox.
Global regulatory restrictions are chief among these challenges, and they continue to tighten. While a waterborne-dominant future is ahead, many biocides traditionally used in paints and coatings for water-based products – including formaldehyde releasers – are facing dosage limitations for consumer markets, especially in Europe. Formulators must overcome challenges in this respect, but it also creates an opportunity for innovation and the adoption of well-established and robust options for the industry.
Reliability of Supply
Paint and coatings preservatives can be limited by occasional raw material shortages. These situations are typically dynamic and temporary, but they can interfere with market demands and the production of products. Formulators need proven alternatives to keep their customers supplied and their factories running.
Preservative suppliers can sometimes find alternative sources of supply for critical biocides during material shortages. More importantly, they can help formulators identify alternative solutions that are approved for use in paint and coating products. This requires a deep understanding of the current regulatory landscape, as well as expertise in microbiology and the formulation of low-VOC and water-based paints.
Microbial control challenges are not easy or simple, which makes collaboration with experienced biocide suppliers critical for selecting preservatives with characteristics for specific formulations – such as speed of kill, long-term efficacy, pH stability range, chemical compatibility, and efficacy against targeted bacteria and fungi. The following are a few biocide options formulators should consider to ensure robustness of their preservative packages.
Readily Biodegradable CMI/MI Preservatives for Cost-Effective Performance
Sometimes referred to as the workhorse preservative for in-can preservation of water-based paints and binders with pH up to 8.5, chloromethylisothiazolone/methylisothiazolone (CMI/MI) is effective at low levels – 0.1 to 0.15% of the finished product. CMI/MI preservatives provide broad-spectrum protection against microorganisms, such as bacteria, yeast and mold fungi, which in turn enables robust preservation of water-based products, including paints, adhesives, latex emulsions, tackifiers, mineral slurries and pigment dispersions.
CMI/MI preservatives are compatible with water-based paints, and typically do not cause coagulation or changes in viscosity, color, gloss, film formation or other critical parameters of the finished formulations.
KATHON™ LX 1.5% is an in-can preservative based on CMI/MI with a broad spectrum of activity, widely used in aqueous industrial products, including water-based paints. Effective against gram-positive and gram-negative, aerobic and anaerobic bacteria, as well as mold and yeast, this product complies with several food contact legislations of the European Union and the U.S. Food and Drug Administration (FDA).
DBNPA as a Co-Preservative
Highly valued as a cost-effective biocide with instantaneous antimicrobial activity and rapid chemical breakdown that swiftly and safely degrades in the environment, 2,2-dibromo-3-nitrilopropionamide (DBNPA) is widely used in paint and coatings manufacturing plants for hygiene purposes. Many paint and coatings producers typically use DBNPA to keep raw materials clean, purify wash water and contaminated products, and as a quick-clean agent for plant equipment. Effective at low concentrations, DBNPA provides a broad-spectrum quick-kill of bacteria, fungi and yeast. It is completely miscible with water, and effective microbial control is often achieved within minutes.
Overlooked by many paint and coatings formulators is the value of DBNPA as a co-preservative in finished products. Adding DBNPA to a paint that contains long-term preservatives, such as CMI/MI, BIT and BIT/ZPT (see below), reduces the bio-burden of other preservatives and supports the paint integrity of paint during its shelf-life. This can lower the chances for field failure, product recall, product rework and downtime.
DOWICIL™ QK-20 antimicrobial is a fast-acting, broad-spectrum DBNPA-based biocide that is ideal for reducing microbiological contamination in products, such as aqueous paints and coatings, latex and resin emulsions, and many other products.
BIT/ZPT Solutions for Broader pH and Higher Fungicidal Performance
Formulators looking for an in-can preservative that is effective against a broad-spectrum of both bacteria and fungi in the wet state should consider 1,2-Benzisothiazolin-3-one/Zinc 2-pyridinethiol-1-oxide (BIT/ZPT). The biocide is highly stable across a wide range of temperatures and pH. A good option for closing the Pseudomonas bacteria gap that exists with other preservatives, BIT/ZPT biocides are water-based dispersions proven to be compatible and effective in a range of latex emulsions, building materials and some paint and coatings applications.
Ideal for applications requiring a pH level above 8.5, new BIOBAN™ BZ antimicrobial containing BIT/ZPT provides strong antifungal properties. The preservative is approved by the U.S. Environmental Protection Agency (EPA) in paint, coating and emulsion applications, as well as formulations in the building and construction space, at dose rates ranging from 0.01 up to 0.4% of the total formulation. Registration for individual U.S. states is currently underway, and the new product is gaining approvals.
Choosing Preservative Supplier Partners for Microbial Solutions
The global regulatory landscape for biocides can be daunting. Regulations and labeling requirements for microbial control products are constantly changing, making it difficult for formulators to remain up-to-date.
For instance, in the United States, antimicrobials must be registered under the Federal Insecticide, Fungicide and Rodenticide Act. Conventional chemicals are subject to regulation under the Toxic Substances Control Act, and paint and coatings products used in the food and personal care markets are subject to regulations under the Federal Food Drug and Cosmetics Act.
In Europe, products must meet the requirements of the European Union’s Biocidal Products Regulation (BPR) – (EU) No 528/2012, along with the ongoing requirement to register products at the national level. In addition, there are requirements under REACH, the European Union regulation for the Registration, Evaluation, Authorization and Restriction of Chemicals. As for the rest of the world, countries typically have their own regulations governing the use of biocides, although in some instances they rely on biocides that have EU BPR or US EPA approval.
Biocide suppliers to the paint and coatings industry should have a working knowledge of these regulations. For instance, Dow Microbial Control routinely helps formulators navigate the intricate web of protocols and procedures to ensure products are properly formulated and registered. The company also actively advocates for science-based regulatory decisions that are appropriate to the risk of exposure for individual markets, including paints and coatings. The potential hazards of specific materials used in the personal care market are not always equivalent in other markets – an important difference that is not always considered by regulatory authorities.
Beyond regulations, it is important to partner with biocide suppliers with a deep understanding of process preservation chemistries, water treatment chemistries, in-can preservatives and the science of paint and coatings formulation at the molecular level. Suppliers should also be capable of providing formulators with plant hygiene audits to identify and remedy all points of microbial contamination, as well as lab capabilities to help optimize product throughput.
Despite a shrinking preservative toolbox, there are still a diverse range of biocide options available to formulators. The good news is that, with the help of an experienced biocide supplier, formulators can identify compatible, approved preservative solutions to navigate the shifting trends of marketplace demands and regulatory mandates.
Looking for a reprint of this article?
From high-res PDFs to custom plaques, order your copy today!






